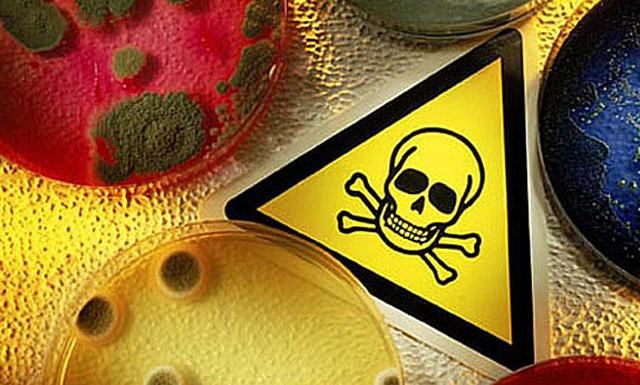
Чоловік помер від лептоспірозу у Львові після купання в озері Чоловік помер від лептоспірозу у Львові після купання в озері

Про це повідомляє Львівський обласний лабораторний центр.
Зазначається, що чоловік під час відпочинку не дотримувався правил особистої гігієни.
Читайте також: Лептоспіроз в Україні: симптоми хвороби
"Хворий за медичною допомогою з приводу захворювання не звертався, займався самолікуванням. На 7-ий день від початку захворювання був госпіталізований в реанімаційний відділ Львівської обласної інфекційної лікарні в дуже важкому стані. На наступний день хворий помер", – мовиться у повідомленні центру.
Додамо, що в Україні за 8 місяців 2017 року зареєстровано 164 випадки захворювань людей на лептоспіроз.
Лептоспіроз – гостре інфекційне захворювання людей і тварин, спричиняється збудником лептоспірою, характеризується ураженням печінки, нирок, м'язів і супроводжується хвилеподібною гарячкою.